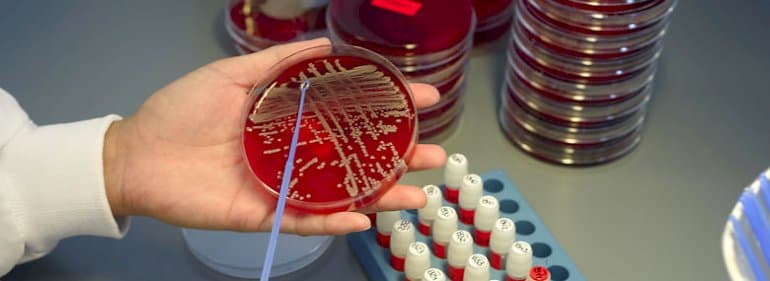

Det bliver blandt andre kommuner, som kommer til at dække tabet efter at Statens Serum Institut blev solgt for billigt til den saudi-arabiske sheik Abdulaziz Hamad Aljomaih, for dele af pengene til at dække underskuddet skal taget fra den pulje, som bekæmper overbelægning på sygehusene. Det skriver Ekstra Bladet.
Det drejer sig blandt andet om 76 mio. kr. fra puljen 'kommunale forebyggelsesindsats med særligt fokus på ældre medicinske patienter og udsatte grupper’. De penge var ellers ifølge finansloven øremærket til en 'styrket indsats mod overbelægning', som der stadig er store problemer med på landets sygehuse.
Puljen var tiltænkt en forebyggende indsats på kommunalt plan rettet mod ældre og svage, så de oftere kunne undgå indlæggelser og dermed ikke lægge yderligere pres på de overfyldte hospitalsafdelinger.
Samlet tab op mod 1,8 milliarder
Sundhedsminister Ellen Trane Nørby (V) mener, at det er ’brandærgerligt’, at de 76 mio. kr. ikke er gået til indsatsen mod overbelægning.
- Puljen blev af forskellige grunde ikke udmøntet i 2016 – og derfor skulle pengene jævnfør budgetreglerne tilbageføres til statskassen igen. Det er brandærgerligt, men sådan er reglerne desværre for puljemidler, skriver hun i en mail til Ekstra Bladet og fortsætter:
- Det blev derfor valgt at bruge bl.a. disse midler til at dække underskuddet hos SSI parallelt med, at regeringspartierne og Dansk Folkeparti skulle styrke indsatsen mod overbelægning og udmønte den samlede plan på 1,2 mia. kr. i perioden 2016-2019 til nedbringelse af overbelægning og en styrket indsats for den ældre medicinske patient.
I november sidste år viste en undersøgelse, at syv ud af 10 sygeplejersker stadig oplever massiv overbelægning, og eksempelvis måtte over 3000 patienter i 2017 ligge på gangen eller andre fællesarealer på Region Sjællands seks sygehuse, fordi der ikke var plads.
Rigsrevisionen kom for nylig med en hård kritik af Sundhedsministeriet for håndteringen af salget, der kommer til at koste skatteyderne mellem 1,3 og 1,8 mia. kr.
Heraf lød underskuddet i forbindelse med salget alene i 2017 på 400 mio. kr.
rp
Tekst, grafik, billeder, lyd og andet indhold på dette website er beskyttet efter lov om ophavsret. DK Medier forbeholder sig alle rettigheder til indholdet, herunder retten til at udnytte indholdet med henblik på tekst- og datamining, jf. ophavsretslovens §11 b og DSM-direktivets artikel 4.
Kunder med IP-aftale/Storkundeaftaler må kun dele DK Sundheds artikler internt til brug for behandling af konkrete sager. Ved deling af konkrete sager forstås journalisering, arkivering eller lignende.
Kunder med personligt abonnement/login må ikke dele DK Sundheds artikler med personer, der ikke selv har et personligt abonnement på DK Sundhed
Afvigelse fra ovenstående kræver skriftligt tilsagn fra DK Medier.